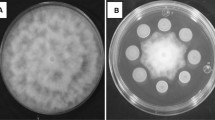

Abstract
Postharvest fungal diseases cause serious fruit losses and food safety issues worldwide. The trend in preventing food loss and waste has shifted to environmentally friendly and sustainable methods, such as biological control. Penicillium expansum is a common postharvest contaminant fungus that causes blue mould disease and patulin formation on apples. This study aimed to provide biocontrol using Metschnikowia pulcherrima isolates against P. expansum, and to understand their antagonistic action mechanisms. In vitro, 38.77–51.69% of mycelial growth inhibition of P. expansum was achieved by M. pulcherrima isolates with the dual culture assay, while this rate was 69.45–84.89% in the disc diffusion assay. The disease symptoms of P. expansum on wounds were reduced by M. pulcherrima, on Amasya apples. The lesion diameter, 41.84 mm after 12 d of incubation in control, was measured as 24.14 mm when treated with the most effective M. pulcherrima DN-MP in vivo. Although the antagonistic mechanisms of M. pulcherrima isolates were similar, there was a difference between their activities. In general, DN-HS and DN-MP isolates were found to be more effective. In light of all these results, it can be said that M. pulcherrima isolates used in the study have an antagonistic effect against the growth of P. expansum both in vitro and in vivo in Amasya apples, therefore, when the appropriate formulation is provided, they can be used as an alternative biocontrol agent to chemical fungicides in the prevention of postharvest diseases.
Graphical Abstract

Similar content being viewed by others
Avoid common mistakes on your manuscript.
Introduction
Postharvest losses due to unfavorable storage and transportation conditions reach 25 and 50% of the total production of fruit in developed and developing countries, respectively [1]. Fungal spoilage is the major reason for the economic losses, which gives rise to nutritional and visual defects in vegetables and fruit during the postharvest period [2]. One of the most prevalent and commercially significant postharvest fruit diseases in the world is blue mould disease, which is caused by Penicillium species, especially Penicillium expansum [3].
P. expansum is one of the most common airborne necrotrophic fungi seen all over the world and may cause losses up to millions of dollars each year by decreasing the quality of fruit, making them inconsumable and causing adverse health effects on consumers due to their secondary metabolites [3, 4]. In addition to the fact that its spores are resistant and easily dispersed, they quickly invade the fruit through the wound and cause softening [5]; it produces more than 50 secondary metabolites, most importantly patulin, that have toxic and carcinogenic effects on consumers [6]. Although P. expansum can use a wide variety of fruit as a host, it mostly affects climacteric fruit, especially pome fruit such as apples and pears [7].
Apple (Malus domestica) is a fruit that owns a nutritional content consisting of various vitamins, minerals, sugars, biologically active compounds [5], phenolic compounds [8] and dietary fiber [3]. Apple is among the highest-produced commodities worldwide [9]. In other respects, the long storage periods of up to 6 months and the lack of fruit resistance against fungal pathogens make apples prone to postharvest decays [3]. About 15–20% of total apple losses are due to blue mould disease caused by P. expansum during storage that generally infects the wounded sites on the fruit [10]. Therefore, controlling the growth of P. expansum and the production of patulin in apples is an important step to protect consumer health and reduce the economic loss of those involved in the food chain from producer to consumer.
Chemical-synthetic fungicides have been widely used to prevent these fungi-induced food losses. However, the excessive usage of these fungicides has increased the fungal strains’ resistance and caused many environmental and health-related issues [11]. Therefore, the demand to produce a new and greener solution has emerged by thoroughly investigating fungi’s pathogenicity and toxicity [12]. Eventually, people have towards biocontrol methods, such as using antagonistic microorganisms, whose studies are gradually increasing [13]. Among the microorganisms involved in biocontrol agents, yeasts are particularly preferred because they mostly do not produce any toxic secondary metabolite, they are Generally Recognized as Safe (GRAS), can grow either in high sugar or acidic environments, have genetic stability and high-speed colonization capability, effective at low concentrations and against various pathogens [14, 15].
Antagonistic yeasts act on fungal pathogens mainly by the action mechanisms of competition for nutrients and space, secretion of antimicrobial compounds such as volatile organic compounds (VOCs), secretion of cell wall degrading enzymes and induction of host defence [2].
Extracellular polymeric substances envelop and attach dense communities of microorganisms as biofilms on fruit surfaces. This constitution is considered a technique for nutrient and space competition occupied by antagonist yeasts [1]. This morphological difference helps yeasts’ antagonism by forming a mechanical barrier between pathogen and fruit, interrupting the signals for spore germination of phytopathogens [16]. Secretion of the red-colored pigment called pulcherrimin is also a prime example of competition for nutrients since an antagonist may release siderophores, which bind to Fe+3 in the environment with very high affinity, evicts iron from the complex structures and cause iron depletion [17, 18]. Because of the important role of iron in fungi pathogenicity, many cellular and metabolic pathways of postharvest pathogens may be eliminated by this mechanism [18].
Secretion of VOCs like aldehydes, alcohols and esters produced by antagonist yeasts are considered potential biological control agents since they are not required to contact pathogens for inhibition effect [1]. These compounds inhibit fungal cultures with the mechanisms of hydrolyzation of the cell wall, induction of host resistance and inhibition of DNA synthesis as well as reducing fungal spore germination, decreasing the length of germ tube and mycelial growth [19].
Besides many action mechanisms owned by antagonists, it has been proved that cell wall degrading enzymes are also effective against pathogens. Tight binding of some antagonistic yeasts to fungal hyphae and secretion of lytic enzymes causes fractional degradation of mycelia [13]. These extracellular enzymes like chitinase, proteases and glucanase are depolymerases that disrupt the cell wall of fungi and cause the release of nutrients for yeasts’ consumption [20].
Metschnikowia pulcherrima are highly favored as biocontrol agents due to several mechanisms against many postharvest pathogens, especially competing for nutrients and space and by producing antimicrobial substances and pulcherrimin [17]. Some studies investigate the biocontrol ability of M. pulcherrima against Botrytis cinerea on grapes [21], Penicillium digitatum and Penicillium italicum on mandarin [22, 23], P. expansum on sweet cherries [24], P. digitatum and P. expansum on lemons [19], P. expansum on grapes [25]. Since antagonistic activity is specific to complex interactions between the antagonistic yeast, the fungal pathogen and the host fruit [14, 15], the activity and the mechanism underlies the antagonism of each antagonistic isolate should be examined, even if only one of the factors is changed.
Therefore, the main goal of the study is to investigate the antagonistic activity of different M. pullcherima strains as a control agent against a major post-harvest disease in apples, which is called blue mold disease. For this purpose, the antagonistic effect of three Metschnikowia pulcherrima isolates from different local sources (grape leaf, corn tassel and hoşkıran) against Penicillium expansum was investigated by both in vitro and in vivo assays on apple fruit, by inoculating yeast before mold formation in order to examine the preventive effectiveness. Besides, the comprehensive study evaluated the production of VOCs and pulcherrimin, lytic enzyme activity, biofilm formation, and spore germination to elucidate the background mechanisms leading to the antagonistic effect.
Materials and Methods
Yeast and Fungal Cultures
Antagonistic yeasts used in this study, Metschnikowia pulcherrima DN-HS, Metschnikowia pulcherrima DN-MP and Metschnikowia pulcherrima DN-UY, were isolated from hoşkıran (Amaranthus retroflexus, a consumable local herb that grows in the Black Sea region of Türkiye), corn tassel and grape leaf collected from Ordu/Türkiye (40.963320, 37.585060), respectively, and identified by Dikmetas et al. [26]. The Genbank accession numbers of M. pulcherrima DN-HS, M. pulcherrima DN-MP and M. pulcherrima DN-UY are PP496773, PP496774 and PP496775, respectively. Yeast cultures were observed under both light microscopy (Nikon Eclipse Ni-U, Japan) and scanning electron microscopy (SEM) at 20 kV, and images are given in Fig. S.1. Penicillium expansum DSM62841 (German Collection of Microorganisms and Cell Cultures GmbH) was used as the fungal pathogen, which produce patulin. All yeast and fungal cultures were obtained from Food Microbiology Laboratory of Istanbul Technical University, Department of Food Engineering. Yeast cultures were grown on Yeast Extract Peptone Dextrose (YEPD) broth at 25 °C for 2 d, and mould culture was cultivated on Potato Dextrose Agar (PDA) at 25 °C for 7 d before the experiments. Culture concentrations were set by making dilutions and counting on a hemocytometer.
Fruit
Amasya apples (Malus domestica) were obtained from a commercial market in Istanbul, Turkey. Uniform and healthy apples were selected randomly and washed with tap water. The surface sterilization of apples was carried out by immersion in 1% (w/v) of sodium hypochlorite (NaOCl) for 2 min. Afterwards, apples were rinsed with sterile distilled water. Then, apples were left to dry with sterile laminar air flow in the biosafety cabinet.
Antagonistic Activity of Metschnikowia Isolates
In Vitro Assays
The in vitro antagonistic activities of Metschnikowia isolates were determined by dual culture [27] and agar plate inhibition assays [28] with slight modifications. For the dual culture assay, 100 µL of each yeast suspension (108 CFU/mL) was spread on PDA as a line 4.5 cm away from the plate’s edge (90 mm). After 2 d of incubation at 25 °C, 5 μL of P. expansum (105 CFU/mL) was inoculated on the same plate by putting a disc 1.5 cm apart from the yeast colonies. For the agar plate inhibition assay, 100 µL of each yeast suspension (108 CFU/mL) was inoculated on PDA by the spread plate technique. After that, all plates were dried, and 5 μL of P. expansum (106 CFU/mL) was inoculated on a disc placed in the middle of the same plates. The plates without yeasts were used as a control.
All plates were incubated at 25 °C until the growth of moulds in control plates reached the plate’s edge. After measuring the radius of the growth area of moulds, the mycelial growth inhibition rate (%) was calculated as I% = (C − T/C) × 100 (I%: mycelial growth inhibition, C: colony diameter (mm) of mould in the control plate, T: the diameter (mm) of mould in the presence of yeast).
In Vivo Assay
The antagonistic effect of yeasts against P. expansum was investigated by the method of Liu et al. [29] with slight modifications. Each sterilized apple was punctured twice using a sterile needle to create artificial wounds (3 mm deep and 3 mm diameter). Each wound was inoculated with 20 μL of 108 CFU/mL yeast suspension and dried at room temperature for 24 h while sterile distilled water was used for the control group. And then 20 μL of P. expansum suspension (105 CFU/mL) was inoculated to each wound. Apples were placed in sterilized plastic packages with 90% relative humidity and incubated at 25 °C. On the 7th and 12th days of incubation, the disease symptoms were examined and the lesion diameters were measured as two perpendicular diameters using a digital calliper (JKTOOL, Resolution: 0.01 mm). By using the obtained data, disease incidence (DI%, (number of decayed wounds/number of total wounds) × 100%) and average lesion diameter (mm) was calculated. “Initial” symptoms were assessed based on the observation of browning tissues, while “deep” symptoms were scored based on the sporulation and/or liquation of tissues. (Fig. S.2). Experiments were carried out in four different plastic packages, each containing four apples.
Effect of Extracellular Metabolites of Yeasts
Effects of Volatile Organic Compounds (VOCs)
Growth inhibition of P. expansum by VOCs of yeast cultures was tested with a slight modification of the method described by Parafati et al. [21]. 100 µL of each yeast suspension (108 CFU/mL) were inoculated on YEPDA by the spread plate technique and incubated for 2 d at 25 °C. And five μL of P. expansum (105 CFU/mL) were inoculated on the center of PDA plates. Each inoculated PDA and 2-d-incubated YEPDA plate were sealed face-to-face with ParafilmR, with YEPDA at the bottom. The yeast-free YEPDA plates were used as a control. All plates were incubated at 25 °C for 7 d. After measuring the radius of the growth area of moulds at 3, 5 and 7th days, the mycelial growth inhibition rate (%) of moulds was calculated as described in Sect. 2.1.1.
Pulcherrimin Production
Pulcherrimin production of antagonistic yeasts under different iron concentrations was determined by the method described by Saravanakumar et al. [30], with some modifications. PDA plates were prepared with iron supplementation at 0, 5, 10, 15 and 20 μg iron/mL concentrations. 100 μL of each yeast isolate (108 CFU/mL) was spread as a line with a 1 cm width at the center of the plate. Plates were incubated at 25 °C for 3 d, and halo width was measured in mm.
Extracellular Lytic Enzyme Activity
Yeast isolates’ lytic enzyme activity, including cellulase, chitinase, lipase, pectinase, protease and β-glucosidase, were visualized on agar plates. Each of the yeast suspensions (107 CFU/mL) was taken from 24 h of yeast culture from YEPD broth and was spot inoculated (10 µL) on a specific solid medium [19].
Cellulase production was evaluated with the YEPD agar plates (10 g/L yeast extract, 20 g/L peptone, 20 g/L glucose, 15 g/L agar) supplemented with 0.4% carboxymethylcellulose. The agar plates were incubated at 30 °C for 5 d. Firstly, the colonies were rinsed with sterile distilled water and stained with 0.1% Congo red for 30 min. Finally, colonies were rinsed off with 1 M NaCl for 15 min. Clear halo zones around the colony indicated the cellulase-positive yeast isolates [31, 32]. The β-glucosidase activity was tested on agar medium (5.0 g of esculin, 20.0 g of peptone from meat, 10.0 g of yeast extract, and 12.0 g of agar) solubilized in 990 mL deionized water. It was vigorously stirred at 100 °C, and pH was arranged to 5.0 before the sterilization (20 min, 121 °C). Before pouring Petri dishes, 10 mL of sterile-filtered ammonium iron (III) citrate solution (1.0% w/v) was added. Esculin was converted to glucose and esculetin on β-glucosidase positive yeast with dark brownish color [32].
Yeast isolates were tested for chitinase activity on colloidal chitin selective medium (1 g/L (NH4)2SO4, 0.2 g/L MgSO4.7H2O, 1.6 g/L K2HPO4, 0.2 g/L KH2PO4, 0.1 g/L NaCl, 0.02 g/L CaCl2.2 H2O, 0.01 g/L FeSO4.7H2O and 15 g/L agar) supplemented wiTh 1.2% colloidal chitin described by [21]. According to Roberts and Selitrennikoff [33], colloidal chitin was prepared from shrimp cell chitin. 5 g of chitin powder was gently added to 60 mL of concentrated HCl, and the mixture was maintained at room temperature for 1 h with vigorous stirring. The obtained mixture was filtered through glass wool, and then 200 mL of 50% ethanol was added to the filtrate with rapid stirring. Then it was centrifuged at 3000 × g for 20 min, and obtained precipitate pH was arranged to neutral (pH 7.0) with washing sterile distilled water. Colloidal chitin solution (10 mg/mL) was kept at 4 °C before the analysis. A clear zone around the colony was used to determine chitinase activity daily after 1–7 d of incubation at 25 °C. After autoclaving at 110 °C for 5 min, protease activity was assayed on milk solid medium (100 g/L skim milk powder, 15 g/L agar). Inoculated plates were examined daily for 7 d at 25 °C incubation. The light halo zone around the colony showed enzymatic activity [29]. Pectinase activity was examined with the enrichment of citrus pectin as a carbon source in a mineral medium (citric pectin, 2.0 g/L; yeast extract 1.0 g/L; agar 15.0 g/L; KH2.PO4 0.2 g/L; CaCl2 0.05 g/L; (NH4)2SO4 1.0 g/L; MgSO4.7H2O 0.8 g/L; MnSO4 0.05 g/L) at pH 4.5 reported by Merín et al. [34]. Lugol’s solutions were added to Petri plates to observe clear halos around the positive colonies after a 48 h incubation period at 28 °C. Lipase production of the yeast isolates was screened with the medium consisting of 10 g/L peptone; 5 g/L NaCl; 0.1 g/L CaCl2.H2O; 20 g/L agar and enriched with 1% (w/v) of Tween 80 at 5.6 pH. The yeast cultures were incubated at 28 °C for 72 h, and the production of clear zones indicated lipase production [35].
Biofilm Formation
The biofilm formation of yeast isolates was examined with a slight modification of the method described by Yang et al. [36]. The cells of M. pulcherrima DN-HS, DN-MP and DN-UY, which were cultured for 24 h at 28 °C in YEPD broth medium, were harvested by centrifugation (6000 rpm, 10 min), washed twice with phosphate-buffered saline (PBS), and the pellet was resuspended in YEPD broth. Each yeast solution adjusted to 107 CFU/mL (100 µL) was pipetted into 3 wells of a 96-well polystyrene plate and incubated at 28 °C for 3 h with 75 g agitation. As a control, YEPD broth was added into wells. After incubation, each well was washed twice with 150 μL of PBS and refilled with 100 μL of YEPD broth. The plates were incubated for 48 and 72 h, while the YEPD broth was changed every 24 h. All experiments were carried out in triplicate. At the end of the incubation, each well was washed with PBS twice and stained with 100 μL of 0.4% aqueous crystal violet solution for 45 min. After staining, each well was washed with 350 μL sterile distilled water four times, and decolourization was carried out with 200 μL of 95% ethanol. After 45 min, the absorbance of the ethanol that transferred to a new well was measured at 590 nm. Control absorbances were subtracted from the absorbances of the biofilm performed plates to eliminate the effect of impurities from the medium.
Spore Germination
The spore germination rate of fungi was investigated with the method described by Ruiz-Mayona et al. [37], with slight modifications. P. expansum spore suspension (100 μL, 108 spores/mL) and 100 μL of yeast suspensions (106 spores/mL) were added into 5 mL of YEPD broth. Only P. expansum-inoculated YEPD broth was used as the control. All tubes were incubated for 12 h at 25 °C and 100 rpm. At least 100 fungal spores in at least 10 microscopic areas were counted to calculate spore germination inhibition. The spore was said to have been germinated when the germ tube length was higher than the spore’s diameter.
Statistical Analysis
All experiments were analyzed statistically using SPSS 28.0 (SPSS Inc., Chicago, IL, USA). Experiments were carried out in three replicates, each consisting of three parallels. Results are expressed as mean ± standard deviation. The differences between mycelial growth inhibition and disease incidence, biofilm formation, pulcherrimin and enzyme secretion, and inhibition of spore germination properties of yeast isolates were compared by one-way analysis of variance (ANOVA). Tukey’s multiple range test was conducted for the mean separation, and differences were considered significant if p < 0.05.
Results
Antagonistic Activity of Metschnikowia Isolates
In Vitro Assay
The antagonistic activity of Metschnikowia isolates to inhibit the growth of Penicillium expansum was evaluated using disc diffusion and dual culture approaches. The data obtained from the disc diffusion assay showed that M. pulcherrima DN-HS showed the highest P. expansum mycelial growth inhibition among other isolates with a significant difference (p < 0.05) (Fig. 1). In dual culture assay, percentage inhibition was observed varying from 38.77 to 51.69%, while the M. pulcherrima DN-MP provided the lowest results.
a In vitro mycelial growth inhibition rates of Metschnikowia pulcherrima isolates (DN-HS, DN-MP, DN-UY) against P. expansum by dual culture and disc diffusion assay on the 12th day of storage. a,bvalues within the same column with the different superscript lowercase are significantly different (p < 0.05). b Antagonistic activity of M. pulcherrima isolates against P. expansum by dual culture and disc diffusion assay on the 12th day of storage
In Vivo Assay
The in vivo efficiency of all isolated Metschnikowia pulcherrima against P. expansum was evaluated on Amasya apples stored at room temperature. All yeasts had a lower lesion diameter ranging from 13.07 to 14.49 mm on the 7th day of storage compared to the control group, and by increasing the storage time to 12 d, a difference was observed among each strain (Fig. 2). The lowest lesion diameter in apple (24.24 mm) was seen as a result of M. pulcherrima DN-MP application, followed by M. pulcherrima DN-UY (30.17 mm) and M. pulcherrima DN-HS (35.07 mm).
a Lesion diameters on apples stored at 25 °C for 12 d.1: Values within the same day with the different superscript lowercase are significantly different (p < 0.05). b Visual effect of Metschnikowia pulcherrima isolates (DN-HS, DN-MP, DN-UY) against Penicillium expansum on Amasya apples. c Effect of Metschnikowia pulcherrima isolates on disease incidence (%) of Amasya apples.2: Disease incidence;3:Values within the same column with the different superscript lowercase are significantly different (p < 0.05)
As seen in Fig. 2, it was observed that apples showed both initial and deep disease symptoms during 12 d of storage. Except for M. pulcherrima DN-MP (62.5%), which showed a statistically significant difference (p < 0.05) from the control group on the 7th day, other strains had no difference from the control (87.5–90.63%), while the highest results in disease incidence were found to be deep disease symptoms with 43.75–78.12%. On the 12th day of the analysis, deep disease symptoms were observed more frequently. Although M. pulcherrima DN-MP in this symptom was statistically different from the control, it was seen that yeasts were ineffective in the disease incidence (%).
Effect of Extracellular Metabolites of Yeasts
Effects of Volatile Organic Compounds (VOCs)
All isolates used in this study showed inhibitory activity against P. expansum by their VOCs. Although there was no significant difference between isolates (p > 0.05), at each incubation period of days, the isolate that reduced the mycelial growth of P. expansum most and least was different (Table 1). The highest inhibition rate belonged to DN-HS on day 3 (29.87%) and to DN-MP (28.78%) on day 5, and the inhibition rates of DN-HS and DN-MP (22.85%) on day 7 were same. On the 7th day of incubation, morphological changes occurred in P. expansum colonies and hyphae treated with M. pulcherrima isolates compared to untreated control (Fig. 3).
Pulcherrimin Production
To examine the effect of the amount of iron in the medium on pigment production of M. pulcherrima isolates, media with 5 different iron concentrations (0, 5, 10, 15, 20 μg/mL) were used. As a result, regardless of the isolates and their initial zones, it was observed that the halo width formed around yeast became smaller, and the color of the pale yeast colonies turned into pink, red and brown colors with the increasing concentration of iron (Fig. 4). In the medium without iron supplementation, M. pulcherrima DN-HS and M. pulcherrima DN-MP isolates showed significantly different pigment formation than M. pulcherrima DN-UY (p < 0.05). There was no halo at M. pulcherrima DN-HS, and M. pulcherrima DN-UY isolates at 15 μg/mL, while M. pulcherrima DN-MP still formed a 1.08 ± 0.38 mm halo. At 20 μg/mL, no halo was seen in each isolate.
a Halo width produced by Metschnikowia pulcherrima isolates (DN-HS, DN-MP, DN-UY) at different iron concentrations. a,b values within the same iron concentration differ significantly (p < 0.05). b Pigmented halo production and color change of colonies of Metschnikowia pulcherrima isolates, depending on the iron concentration
Extracellular Lytic Enzyme Activity
All isolates used in this study, M. pulcherrima DN-HS, DN-MP and DN-UY, showed almost the same extracellular lytic enzyme activity (Table 2). Except for M. pulcherrima DN-UY, the other 2 isolates were β-glucosidase, chitinase, protease and lipase positive, cellulase and pectinase negative.
Biofilm Formation
While M. pulcherrima DN-HS was the isolate with the best-adhering ability on polystyrene plates and biofilm formation capability, DN-UY showed the least biofilm formation. Although the elongation of the incubation period from 48 to 72 h caused a slight decrease in the biofilm formation, the absorbance of all isolates after repeated washings and 72 h incubation showed that each isolate has the capability of forming biofilms. There was a significant difference (p < 0.05) between all three isolates’ biofilm formation capabilities after 72 h (Table 3).
Spore Germination
All yeast isolates inhibited the spore germination of P. expansum (Fig. 5). P. expansum showed 100% spore germination. Although M. pulcherrima DN-HS was the isolate that caused the highest inhibition of spore germination, even DN-UY, which had the lowest effect, showed an inhibition efficiency of over 80% (p < 0.05).
Discussion
Three M. pulcherrima isolates were tested against P. expansum, a potential risk in apples. The antagonistic activities of these yeasts, the effects of their pulcherrimin production, their extracellular metabolites, biofilm formation and spore germination were investigated.
All of the Metschnikowia pulcherrima isolates showed the ability to reduce P. expansum’s mycelial growth above 69 and 38% according to disc diffusion and dual culture assay, respectively (Fig. 1). In contrast to Oztekin and Karbancioglu-Guler [19], no Metschnikowia isolate completely inhibited mycelial growth. However, it is seen that studies examining antagonistic activities show variable results depending on the incubation time as well as different strains of the same species. Settier-Ramírez et al. [38] investigated the M. pulcherrima strains against P. expansum. They obtained varying results depending on both yeast concentration and incubation time in addition to the difference caused by strain.
The in vivo antagonistic effect of the isolates was demonstrated on the 7th and 12th days of storage of Amasya apples. There was no correlation between the antagonistic activities of the isolates according to the results of in vivo and in vitro studies, just like in the study of Parafati et al. [21], in which the isolate with the lowest activity in vitro was found to be the most effective in vivo. They stated that the most effective yeast in vitro tests were Aerobasidium pullulans at pH 6 and Wickerhamomyces anomalus at pH 4.5, while in the in vivo analysis on grapes, Metschnikowia pulcherrima MPR3 was found to be the most effective. As the nutrients in the environment change, the production of secondary metabolites that are effective in pathogen inhibition may change [39]. For this reason, it can be interpreted that the differences in the medium and the nutrients in the apple may cause the activity of the isolates to change. While it is seen that studies investigating the antagonistic effect of Metschnikowia species against P. expansum have been tested on different fruit, such as sweet cherries [24], it is important to focus the studies on apples since P. expansum causes serious loss of apples [40]. The highest lesion diameter on the apples was seen in the case of M. pulcherrima DN-HS treatment on the 12th day of storage, among other strains. Similarly, Settier-Ramírez et al. [38] found that the lesion diameter in apples treated with M. pulcherrima was around 35 mm. It was statistically different and lower than the control group until the 13th day of storage. However, as the storage time increased, the statistical difference with the control group disappeared. Therefore, since the antagonistic effect may decrease with the extension of the storage period, the analysis was carried out at 12 d of storage.
Microorganisms producing VOCs are promising in biocontrol due to their activity without any contact [15], and some studies indicate the antagonistic activity of VOCs of various M. pulcherrima isolates against Monilinia laxa [41], Botrytis cinerea [21], Pestalotiopsis vismiae [36], Penicillium digitatum and P. expansum [19]. Despite the VOCs of yeasts being dependent on both strain and targeted fungi [17], they are associated with the antagonistic activity of yeast against fungi, and M. pulcherrima was found to produce ethyl acetate, isoamyl alcohol, amylic alcohol, 2-phenyl-ethanol [41], 3-methyl-1-butanol, 1-hexanol and 2(3H)-Furanone, dihydro-5-pentyl [36]. When our results were examined in general, it was seen that the effects of VOCs produced by M. pulcherrima isolates used against P. expansum growth were slightly decreased during the incubation period. This inverse proportion with the incubation period and inhibition rate were in line with the findings of Dikmetas et al. [26]. It can be explained as the VOCs are being released at the highest level after 54–72 h from the yeast colonies starting to grow [42] and may decrease after 5 d [43]. It is possible to increase the inhibition efficiency of antagonistic yeasts’ VOCs by mixing cultures instead of using only one [44] or immobilizing yeasts on hydrogel spheres [23]. Similar to Farbo et al. [45], morphological changes as more branched, sparser and extended hyphae were observed on the 7th day of incubation at yeast-treated colonies than in untreated colonies (Fig. 3). Alike, by the effect of antagonistic yeasts’ VOCs, damages to the conidial and hyphal structures of Aspergillus flavus were reported [46]. The fact that the VOCs of the yeasts also cause P. expansum mycelial growth inhibition shows that the isolates can be used in biocontrol without direct contact, thanks to their volatile component.
As a result of the interaction with Fe+3 in the medium where the antagonist yeast secretes pulcherriminic acid, a red-colored pigment called pulcherrimin is formed. Since pulcherrimin causes iron depletion in the medium and cannot be diffused, so does not play an iron carrier role. It inhibits iron-requiring microorganisms [17]. In this study, pulcherrimin production of M. pulcherrima isolates was investigated in media with different iron concentrations since it was presented in a previous study that there is a positive correlation between the amount of pigment production and the antagonistic effect, also the mutant non-pulcherrimin producer Metschnikowia spp. which were not able to perform an antagonistic activity [47]. All M. pulcherrima isolates were white and pale without any iron supplementation. With the increasing iron concentration, while the color of yeast colonies turned pink, red and lastly brownish-red, the halo width decreased and became zero at 15 or 20 μg/mL. Oztekin & Karbancioglu-Guler explained this situation by increasing iron ions in the medium; pulcherriminic acid binds near the yeast and forms pulcherrimin before it can diffuse much into the medium [19]. In our study, the halo widths in medium without iron supplementation were 10.67 ± 0.76, 10.33 ± 1.15, and 5.83 ± 0.29 mm for DN-HS, DN-MP and DN-UY, respectively. Similar to our results, it was found between 1 and 5 mm [48], 7.5 mm [30] and > 7.6 mm [21] for M. pulcherrima. It can be claimed that the antagonistic mechanism strongly involves iron depletion since M. pulcherrima isolates used in this study have intense pigment production and form a halo inversely proportional to the iron concentration.
The extracellular lytic enzyme activity is strongly attributed to the antagonistic activity of yeasts since it is possible to degrade fungal cell walls and hinder spore germination through enzymes [13]. The main structure of the fungal cell wall consists of chitin, glucan and protein. While glucan, a filling polysaccharide part in the structure, buildup 50–60% of the cell wall, the remaining 40–50% is made up of a mixture of chitin and protein [2]. Yeasts disintegrate fungal cell walls to reach carbon sources and amino acids for their viability [20]. Cellulose and pectin are also important plant pathogens’ and plants’ cell wall components, respectively. Since the activity of pectinase gives rise to softening and reducing the biomass of fruit, it is unwanted [49]. In light of this knowledge, it can be said that it also plays a substantial role in the inhibition mechanism of antagonists against P. expansum that the isolates used in this study being β-glucosidase, chitinase, protease and lipase positive. Still, they will not cause undesirable effects such as softening in the fruit they are applied to as they are pectinase and cellulase negative. However, according to Fernandez-San Millan et al. [48], lytic enzyme secretion by yeast is effective in the mechanism, but it is not obligatory and should be evaluated together with other mechanisms. This suggestion also supports our result that there was no diversity between the enzymatic activities of M. pulcherrima DN-HS, DN-MP and DN-UY isolates used in this study. Still, both in vitro and in vivo inhibition rates were different. In the literature, each enzymatic activity may differ due to different M. pulcherrima strains. Although the enzymes produced by the yeast isolates used in our study were generally compatible with the literature, unlikely, there are other M. pulcherrima strains that produce cellulase and pectinase are also available [19, 31, 49]. Quite differently, Parafati et al. claimed that the M. pulcherrima isolate they studied had no enzyme activity [21].
Biofilm, the adhesion of microorganisms to each other, proliferation and the formation of an extracellular matrix, makes microorganisms easier to colonize fruit surfaces and destroy pathogens [15]. In support of and opposite this, a positive and no correlation was found between biofilm formation and wound colonization of M. pulcherrima and Aureobasidium pullulans, respectively [21]. Our study showed that all isolates of M. pulcherrima were able to form biofilms but at different levels. The biofilm formation capability of an M. pulcherrima isolate used in a study was found to be lower than DN-HS and DN-MP but higher than DN-UY [36], while another M. pulcherrima isolate was found to be lower than DN-HS, but higher than DN-MP and DN-UY [21]. All these results support that the biofilm-forming capabilities of different strains of microorganisms belonging to the same species may vary, just as the isolates used in our study showed different adhesion in the polystyrene wells. In another study, the OD590 values of Pichia kudriavzevii, Kluyveromyces marxianus, and Yarrowia lipolytica isolates after 48 h incubation were all lower than the values found in our research [50], which indicates that the biofilm formation capabilities of M. pulcherrima isolates were higher than our yeast isolates. However, as a result of our study, since the isolates with the highest activity in biofilm formation and in vivo analyzes were variable, a relationship between biofilm-forming ability and in vivo antagonistic activity could not be established, similar to Fernandez-San Millan et al. [48]. This may be because the most dominant mechanism of each isolate varies, and the synergistic effect of biofilm formation with other mechanisms could be examined in future studies.
Inhibition of fungal spore germination is critical for antagonism, and the main parameter in determining this activity is the concentration of the antagonist [37]. The concentration applied in this study caused over 80% inhibition of spore germination, and it may be possible to increase the yeast concentration for a more effective biocontrol. As well, in a study by Öztekin and Karbancioglu-Guler, it was observed that spore germination inhibition was increased with the use of antagonistic yeasts not individually but in combination [22].
According to all the results given in the study, it is seen that all three M. pulcherrima strains have shown all the mechanisms investigated. When the mechanisms are examined, the effect in all of them was DN-HS, DN-MP and DN-UY, respectively, from high to low. While the effect difference between isolates was small in spore germination and VOCs mechanisms, the biofilm and pulcherrimin production was quite low in DN-UY compared to the other two isolates. While the enzyme production of DN-HS and DN-MP was the same, DN-UY differed only with less production of the β-glucosidase enzyme. Considering all these, it can be said that even strains belonging to the same species of a microorganism can have different antagonistic mechanism activities. Also, this study supports the idea that in vitro and in vivo results are frequently inconsistent by artificial nutrient media, the natural components in fruit cannot be directly simulated, and the activities of antagonists on fruit change.
Conclusion
In the study, all tested M. pulcherrima yeast cultures had fungistatic activity against P. expansum. However, it can be said that M. pulcherrima DN-MP was the least effective in vitro, whereas it was the most effective in vivo. This study showed that even different strains of yeast belonging to the same genus and species might have different antagonistic effects and mechanisms of action. It is indicated that M. pulcherrima can be used to be manage postharvest fruit disease by this research. Additional research is required to examine the capacity to break down patulin in apples. Furthermore, the safety of yeast isolates needs to be assessed in order to evaluate its potential use in the biological control of fungal and mycotoxin contamination in agricultural products. This finding provides a scientific basis for the development of novel and effective food-grade antagonists. Further research is required to investigate the biocontrol mechanism of M. pulcherrima in apples. The goal is to develop more efficient and environmentally friendly solutions for decreasing fungal damage in apples.
Data Availability
Data available on request from the authors.
References
Zhang X, Li B, Zhang Z, Chen Y, Tian S (2020) Antagonistic yeasts: a promising alternative to chemical fungicides for controlling postharvest decay of fruit. J Fungi 6:158. https://doi.org/10.3390/jof6030158
Oztekin S, Dikmetas DN, Devecioglu D, Acar EG, Karbancioglu-Guler F (2023) Recent insights into the use of antagonistic yeasts for sustainable biomanagement of postharvest pathogenic and mycotoxigenic fungi in fruits with their prevention strategies against mycotoxins. J Agric Food Chem 71:9923–9950. https://doi.org/10.1021/acs.jafc.3c00315
Luciano-Rosario D, Keller NP, Jurick WM II (2020) Penicillium expansum: biology, omics, and management tools for a global postharvest pathogen causing blue mould of pome fruit. Mol Plant Pathol 21:1391–1404. https://doi.org/10.1111/mpp.12990
Erper İ, Kalkan Ç, Kaçar G, Türkkan M (2019) Elmada mavi küfe neden olan Penicillium expansum’a karşı bazı bor tuzlarının antifungal etkisi. ANADOLU J Agric Sci 34:250–258. https://doi.org/10.7161/omuanajas.515031
Lin R, Yang Q, Xiao J, Solairaj D, Ngea GLN, Zhang H (2022) Study on the biocontrol effect and physiological mechanism of Hannaella sinensis on the blue mold decay of apples. Int J Food Microbiol 382:109931. https://doi.org/10.1016/j.ijfoodmicro.2022.109931
Andersen B, Smedsgaard J, Frisvad JC (2004) Penicillium expansum : consistent production of patulin, chaetoglobosins, and other secondary metabolites in culture and their natural occurrence in fruit products. J Agric Food Chem 52:2421–2428. https://doi.org/10.1021/jf035406k
Errampalli D (2014) Chapter 6—Penicillium expansum (blue mold). In: Bautista-Baños S (ed) Postharvest decay. Academic Press, San Diego, pp 189–231
Corona-Leo LS, Meza-Márquez OG, Hernández-Martínez DM (2021) Effect of in vitro digestion on phenolic compounds and antioxidant capacity of different apple (Malus domestica) varieties harvested in Mexico. Food Biosci 43:101311. https://doi.org/10.1016/j.fbio.2021.101311
Zhong L, Carere J, Lu Z, Lu F, Zhou T (2018) Patulin in apples and apple-based food products: the burdens and the mitigation strategies. Toxins 10:475. https://doi.org/10.3390/toxins10110475
Gong D, Bi Y, Jiang H, Xue S, Wang Z, Li Y, Zong Y, Prusky D (2019) A comparison of postharvest physiology, quality and volatile compounds of ‘Fuji’ and ‘Delicious’ apples inoculated with Penicillium expansum. Postharvest Biol Technol 150:95–104. https://doi.org/10.1016/j.postharvbio.2018.12.018
Hernandez-Montiel LG, Droby S, Preciado-Rangel P, Rivas-García T, González-Estrada RR, Gutiérrez-Martínez P, Ávila-Quezada GD (2021) A sustainable alternative for postharvest disease management and phytopathogens biocontrol in fruit: antagonistic yeasts. Plants 10:2641. https://doi.org/10.3390/plants10122641
Zhou T, Wang X, Luo J, Ye B, Zhou Y, Zhou L, Lai T (2018) Identification of differentially expressed genes involved in spore germination of Penicillium expansum by comparative transcriptome and proteome approaches. MicrobiologyOpen 7:e00562. https://doi.org/10.1002/mbo3.562
Dukare AS, Paul S, Nambi VE, Gupta RK, Singh R, Sharma K, Vishwakarma RK (2019) Exploitation of microbial antagonists for the control of postharvest diseases of fruits: a review. Crit Rev Food Sci Nutr 59:1498–1513. https://doi.org/10.1080/10408398.2017.1417235
Liu J, Sui Y, Wisniewski M, Droby S, Liu Y (2013) Review: Utilization of antagonistic yeasts to manage postharvest fungal diseases of fruit. Int J Food Microbiol 167:153–160. https://doi.org/10.1016/j.ijfoodmicro.2013.09.004
Spadaro D, Droby S (2016) Development of biocontrol products for postharvest diseases of fruit: the importance of elucidating the mechanisms of action of yeast antagonists. Trends Food Sci Technol 47:39–49. https://doi.org/10.1016/j.tifs.2015.11.003
Chi M, Li G, Liu Y, Liu G, Li M, Zhang X, Sun Z, Sui Y, Liu J (2015) Increase in antioxidant enzyme activity, stress tolerance and biocontrol efficacy of Pichia kudriavzevii with the transition from a yeast-like to biofilm morphology. Biol Control 90:113–119. https://doi.org/10.1016/j.biocontrol.2015.06.006
Sipiczki M (2020) Metschnikowia pulcherrima and related pulcherrimin-producing yeasts: fuzzy species boundaries and complex antimicrobial antagonism. Microorganisms 8:1029. https://doi.org/10.3390/microorganisms8071029
Wang S, Zhang H, Ruan C, Yi L, Deng L, Zeng K (2021) Metschnikowia citriensis FL01 antagonize Geotrichum citri-aurantii in citrus fruit through key action of iron depletion. Int J Food Microbiol 357:109384. https://doi.org/10.1016/j.ijfoodmicro.2021.109384
Oztekin S, Karbancioglu-Guler F (2021) Bioprospection of Metschnikowia sp. isolates as biocontrol agents against postharvest fungal decays on lemons with their potential modes of action. Postharvest Biol Technol 181:111634. https://doi.org/10.1016/j.postharvbio.2021.111634
Hernandez-Montiel LG, Gutierrez-Perez ED, Murillo-Amador B, Vero S, Chiquito-Contreras RG, Rincon-Enriquez G (2018) Mechanisms employed by Debaryomyces hansenii in biological control of anthracnose disease on papaya fruit. Postharvest Biol Technol 139:31–37. https://doi.org/10.1016/j.postharvbio.2018.01.015
Parafati L, Vitale A, Restuccia C, Cirvilleri G (2015) Biocontrol ability and action mechanism of food-isolated yeast strains against Botrytis cinerea causing post-harvest bunch rot of table grape. Food Microbiol 47:85–92. https://doi.org/10.1016/j.fm.2014.11.013
Öztekin S, Karbancioglu-Guler F (2023) Biological control of green mould on mandarin fruit through the combined use of antagonistic yeasts. Biol Control 180:105186. https://doi.org/10.1016/j.biocontrol.2023.105186
Parafati L, Vitale A, Restuccia C, Cirvilleri G (2017) Performance evaluation of volatile organic compounds by antagonistic yeasts immobilized on hydrogel spheres against gray, green and blue postharvest decays. Food Microbiol 63:191–198. https://doi.org/10.1016/j.fm.2016.11.021
de Paiva E, Serradilla MJ, Ruiz-Moyano S, Córdoba MG, Villalobos MC, Casquete R, Hernández A (2017) Combined effect of antagonistic yeast and modified atmosphere to control Penicillium expansum infection in sweet cherries cv. Ambrunés Int J Food Microbiol 241:276–282. https://doi.org/10.1016/j.ijfoodmicro.2016.10.033
Rodriguez Assaf LA, Pedrozo LP, Nally MC, Pesce VM, Toro ME, Castellanos de Figueroa LI, Vazquez F (2020) Use of yeasts from different environments for the control of Penicillium expansum on table grapes at storage temperature. Int J Food Microbiol 320:108520. https://doi.org/10.1016/j.ijfoodmicro.2020.108520
Dikmetas DN, Özer H, Karbancıoglu-Guler F (2023) Biocontrol potential of antagonistic yeasts on in vitro and in vivo aspergillus growth and its AFB1 production. Toxins 15:402. https://doi.org/10.3390/toxins15060402
Huang R, Che HJ, Zhang J, Yang L, Jiang DH, Li GQ (2012) Evaluation of Sporidiobolus pararoseus strain YCXT3 as biocontrol agent of Botrytis cinerea on post-harvest strawberry fruits. Biol Control 62:53–63. https://doi.org/10.1016/j.biocontrol.2012.02.010
Medina-Córdova N, López-Aguilar R, Ascencio F, Castellanos T, Campa-Córdova AI, Angulo C (2016) Biocontrol activity of the marine yeast Debaryomyces hansenii against phytopathogenic fungi and its ability to inhibit mycotoxins production in maize grain (Zea mays L.). Biol Control 97:70–79. https://doi.org/10.1016/j.biocontrol.2016.03.006
Liu Y, Yao S, Deng L, Ming J, Zeng K (2019) Different mechanisms of action of isolated epiphytic yeasts against Penicillium digitatum and Penicillium italicum on citrus fruit. Postharvest Biol Technol 152:100–110. https://doi.org/10.1016/j.postharvbio.2019.03.002
Saravanakumar D, Ciavorella A, Spadaro D, Garibaldi A, Gullino ML (2008) Metschnikowia pulcherrima strain MACH1 outcompetes Botrytis cinerea, Alternaria alternata and Penicillium expansum in apples through iron depletion. Postharvest Biol Technol 49:121–128. https://doi.org/10.1016/j.postharvbio.2007.11.006
Escribano R, González-Arenzana L, Garijo P, Berlanas C, López-Alfaro I, López R, Gutiérrez AR, Santamaría P (2017) Screening of enzymatic activities within different enological non-Saccharomyces yeasts. J Food Sci Technol 54:1555–1564. https://doi.org/10.1007/s13197-017-2587-7
Pretscher J, Fischkal T, Branscheidt S, Jäger L, Kahl S, Schlander M, Thines E, Claus H (2018) Yeasts from different habitats and their potential as biocontrol agents. Fermentation 4:31. https://doi.org/10.3390/fermentation4020031
Roberts WK, Selitrennikoff CP (1988) Plant and bacterial chitinases differ in antifungal activity. Microbiology 134:169–176. https://doi.org/10.1099/00221287-134-1-169
Merín MG, Mendoza LM, Farías ME, Morata de Ambrosini VI (2011) Isolation and selection of yeasts from wine grape ecosystem secreting cold-active pectinolytic activity. Int J Food Microbiol 147:144–148. https://doi.org/10.1016/j.ijfoodmicro.2011.04.004
Knob A, Izidoro SC, Lacerda LT, Rodrigues A, de Lima VA (2020) A novel lipolytic yeast Meyerozyma guilliermondii: efficient and low-cost production of acid and promising feed lipase using cheese whey. Biocatal Agric Biotechnol 24:101565. https://doi.org/10.1016/j.bcab.2020.101565
Yang H, Wang L, Li S, Gao X, Wu N, Zhao Y, Sun W (2021) Control of postharvest grey spot rot of loquat fruit with Metschnikowia pulcherrima E1 and potential mechanisms of action. Biol Control 152:104406. https://doi.org/10.1016/j.biocontrol.2020.104406
Ruiz-Moyano S, Martín A, Villalobos MC, Calle A, Serradilla MJ, Córdoba MG, Hernández A (2016) Yeasts isolated from figs (Ficus carica L.) as biocontrol agents of postharvest fruit diseases. Food Microbiol 57:45–53. https://doi.org/10.1016/j.fm.2016.01.003
Settier-Ramírez L, López-Carballo G, Hernández-Muñoz P, Fontana A, Strub C, Schorr-Galindo S (2021) New isolated Metschnikowia pulcherrima strains from apples for postharvest biocontrol of Penicillium expansum and patulin accumulation. Toxins 13:397. https://doi.org/10.3390/toxins13060397
Spadaro D, Vola R, Piano S, Gullino ML (2002) Mechanisms of action and efficacy of four isolates of the yeast Metschnikowia pulcherrima active against postharvest pathogens on apples. Postharvest Biol Technol 24:123–134. https://doi.org/10.1016/S0925-5214(01)00172-7
Wang K, Ngea GLN, Godana EA, Shi Y, Lanhuang B, Zhang X, Zhao L, Yang Q, Wang S, Zhang H (2021) Recent advances in Penicillium expansum infection mechanisms and current methods in controlling P. expansum in postharvest apples. Crit Rev Food Sci Nutr. https://doi.org/10.1080/10408398.2021.1978384
Oro L, Feliziani E, Ciani M, Romanazzi G, Comitini F (2018) Volatile organic compounds from Wickerhamomyces anomalus, Metschnikowia pulcherrima and Saccharomyces cerevisiae inhibit growth of decay causing fungi and control postharvest diseases of strawberries. Int J Food Microbiol 265:18–22. https://doi.org/10.1016/j.ijfoodmicro.2017.10.027
Di Francesco A, Ugolini L, Lazzeri L, Mari M (2015) Production of volatile organic compounds by Aureobasidium pullulans as a potential mechanism of action against postharvest fruit pathogens. Biol Control 81:8–14. https://doi.org/10.1016/j.biocontrol.2014.10.004
Contarino R, Brighina S, Fallico B, Cirvilleri G, Parafati L, Restuccia C (2019) Volatile organic compounds (VOCs) produced by biocontrol yeasts. Food Microbiol 82:70–74. https://doi.org/10.1016/j.fm.2019.01.008
Agirman B, Erten H (2020) Biocontrol ability and action mechanisms of Aureobasidium pullulans GE17 and Meyerozyma guilliermondii KL3 against Penicillium digitatum DSM2750 and Penicillium expansum DSM62841 causing postharvest diseases. Yeast 37:437–448. https://doi.org/10.1002/yea.3501
Farbo MG, Urgeghe PP, Fiori S, Marcello A, Oggiano S, Balmas V, Hassan ZU, Jaoua S, Migheli Q (2018) Effect of yeast volatile organic compounds on ochratoxin A-producing Aspergillus carbonarius and A. ochraceus. Int J Food Microbiol 284:1–10. https://doi.org/10.1016/j.ijfoodmicro.2018.06.023
Natarajan S, Balachandar D, Senthil N, Velazhahan R, Paranidharan V (2022) Volatiles of antagonistic soil yeasts inhibit growth and aflatoxin production of Aspergillus flavus. Microbiol Res 263:127150. https://doi.org/10.1016/j.micres.2022.127150
Sipiczki M (2006) Metschnikowia strains isolated from botrytized grapes antagonize fungal and bacterial growth by iron depletion. Appl Environ Microbiol 72:6716–6724. https://doi.org/10.1128/AEM.01275-06
Fernandez-San Millan A, Larraya L, Farran I, Ancin M, Veramendi J (2021) Successful biocontrol of major postharvest and soil-borne plant pathogenic fungi by antagonistic yeasts. Biol Control 160:104683. https://doi.org/10.1016/j.biocontrol.2021.104683
Fernandez-San Millan A, Farran I, Larraya L, Ancin M, Arregui LM, Veramendi J (2020) Plant growth-promoting traits of yeasts isolated from Spanish vineyards: benefits for seedling development. Microbiol Res 237:126480. https://doi.org/10.1016/j.micres.2020.126480
Delali KI, Chen O, Wang W, Yi L, Deng L, Zeng K (2021) Evaluation of yeast isolates from kimchi with antagonistic activity against green mold in citrus and elucidating the action mechanisms of three yeast: P. kudriavzevii, K. marxianus, and Y. lipolytica. Postharvest Biol Technol 176:111495. https://doi.org/10.1016/j.postharvbio.2021.111495
Acknowledgements
This research did not receive any specific grant from funding agencies in the public, commercial, or not-for-profit sectors.
Author information
Authors and Affiliations
Contributions
Emine Gizem Acar, Dilara Nur Dikmetas, Dilara Devecioglu: Investigation, Validation, Methodology, Resources, Writing—original draft; Elif Mehves Ozer, Huseyin Sarikece: Investigation, Methodology. Funda Karbancioglu-Guler: Supervision, Project administration, Writing—review & editing, Funding acquisition. All authors have read and agreed to the published version of the manuscript.
Corresponding author
Ethics declarations
Conflict of interest
Authors declare no financial or non-financial interests that are directly or indirectly related to the work.
Additional information
Publisher's Note
Springer Nature remains neutral with regard to jurisdictional claims in published maps and institutional affiliations.
Supplementary Information
Below is the link to the electronic supplementary material.
Rights and permissions
Springer Nature or its licensor (e.g. a society or other partner) holds exclusive rights to this article under a publishing agreement with the author(s) or other rightsholder(s); author self-archiving of the accepted manuscript version of this article is solely governed by the terms of such publishing agreement and applicable law.
About this article
Cite this article
Acar, E.G., Dikmetas, D.N., Devecioglu, D. et al. Antagonistic Activities of Metschnikowia pulcherrima Isolates Against Penicillium expansum on Amasya Apples. Curr Microbiol 81, 180 (2024). https://doi.org/10.1007/s00284-024-03700-1
Received:
Accepted:
Published:
DOI: https://doi.org/10.1007/s00284-024-03700-1